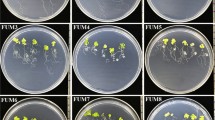

Abstract
Rhizobacteria are central components of the plant microbiome and influence root development and function. Desciphering how rhizobacteria contribute to plant performance under adverse environments is a major research challenge. The aims of the present study were to isolate and characterize rhizobacteria from the halophilic grass Distichlis spicata and to test their possible growth promoting and salt protective properties in Arabidopsis thaliana, Cucumis sativus, and Citrullus lanatus. To determine their possible plant growth promoting properties, 38 rhizobacterial isolates were co-cultivated with Arabidopsis seedlings in vitro. Out of these, two halophilic bacteria, LBEndo1 and KBEcto4, were selected following their strong shoot and root biostimulation. 16S rRNA sequencing identified LBEndo1 as Bacillus sp. and KBEcto4 as Pseudomonas lini. Both strains improved growth under standard and saline conditions, which correlated with IAA and siderophore production, as well as phosphate solubilization. Additionally, the KBEcto4 strain expresses the ACC deaminase enzyme (acdS gene), and slightly increases auxin redistribution within Arabidopsis roots expressing an auxin-inducible gene construct. These data reveal the potential of saltgrass (Distichlis spicata) rhizobacteria to promote growth and confer salt tolerance to Arabidopsis and crop plants.
Similar content being viewed by others
Avoid common mistakes on your manuscript.
1 Introduction
The rhizosphere microbiome has great influence on plant health and performance under environmental stress via their many beneficial traits that include, but are not limited to phytohormone production, release of volatile organic compounds, quorum-sensing modulated root development, nutrient solubilization and/or activation of the plant immune system (Newton et al. 2010; Berendsen et al. 2012; Mapelli et al. 2013; Tian and Gao 2014).
Certain species of Plant Growth Promoting Rhizobacteria (PGPR) may influence their plant hosts through direct or indirect mechanisms (Kloepper and Schroth 1978). Indirect effects include production of antibiotics, suppression of pathogens by competitive exclusion or through competition for nutrients, release of extracellular hydrolytic enzymes, and removal of phytotoxic substances (Glick 1995; Figueiredo et al. 2008; Swain et al. 2008; Siddikee et al. 2010; Bhattacharyya and Jha 2012). On the other hand, the direct mechanisms include improved plant nutrition through phosphate and micronutrient solubilization, acquisition of iron via siderophores, nitrogen fixation, production of phytoregulators such as indole-3-acetic acid (IAA), cytokinin and gibberellins or via the production of 1-aminocyclopropane-1-carboxilic acid (ACC) deaminase, an enzyme that can lower plant ethylene levels (Bashan and de-Bashan 2010; Hayat et al. 2010; Siddikee et al. 2010).
Soil salinization is one of the major problems affecting approximately 800 million hectares of land throughout the world (Bot et al. 2000; FAO 2008). The productivity of agricultural crops is greatly affected by salinity, which typically challenges germination, plant phase transitions, growth and crop yield (Khan and Panda 2008; Forni et al. 2017). Electrical conductivity (EC) of saline soils exceeds 4 dSm−1 and is common to arid and semiarid areas (Munns 2005; Jamil et al. 2011). In these regions, there is a diversity of native plants, well-adapted to survive and reproduce and some halophyte plants establish associations with bacteria with dual capabilities of tolerating high salinity and promoting plant growth (Dimkpa et al. 2009). The use of salt-tolerant PGPR might represent a promising strategy to better adapt crops to saline soils, but their mechanisms of phytostimulation and plant developmental responses remain to be characterized (Mayak et al. 2004; Jha et al. 2012).
Distichlis spicata (L.) E. Greene (Poaceae), commonly called Saltgrass, is a dioecious, perennial grass with extensive asexual propagation via rhizomes and tillers (Hitchcock 1971; Eppley et al. 2009). It is widely distributed in coastal and inland saline habitats from North America to South America, including ponds with high salt content in the Chihuahuan Desert area, due to its efficient salt-avoidance mechanisms such as high osmotic pressure in the cells and excretion of salt through leaf glands (Ungar 1974; Hansen et al. 1976; Allen and Cunningham 1983; Ram et al. 2004; Eppley et al. 2009).
The rhizosphere of saltgrass represents a promissory environment for the establishment of beneficial microorganisms with the ability to withstand high salt concentrations, and to provide a benefit for the plant host. In arid and semiarid areas, the salt-tolerant PGPR have begun to emerge as an important alternative to recuperate abandoned farmlands affected by salinity since the bacteria may alleviate salt stress. This makes necessary bioprospection strategies to isolate and catalogue the bacteria as well as to investigate the plant responses in heterologous plant hosts.
The present study was conducted to characterize PGPR from roots of Distichlis spicata from the Mexican Chihuahuan Desert. We report on the properties of two bacterial isolates typified as Bacillus sp. and Pseudomonas lini, which promote growth of Arabidopsis, cucumber (Cucumis sativus), and watermelon (Citrullus lanatus) seedlings and confer protection against salinity. The data highlight the potential of halophytic bacteria as PGPR and their several possible mechanisms of phytostimulation.
2 Material and methods
2.1 Rhizosphere sampling and isolation of rhizobacteria
Distichlis spicata rhizosphere and root samples were collected from an edge of the pool called “Poza Salada” in the Valley of Sobaco, located southeast of the Chihuahuan Desert in the state of Coahuila, Mexico [(Fig. 1a) (26°10´54″ N and 102°42′24″ W)] (Czaja et al. 2014). The sampling was conducted in the winter of 2013. Saltgrass (Distichlis spicata specimen was authenticated by Jaime Sánchez-Salas of the Herbarium of the Facultad de Ciencias Biológicas of Universidad Juárez del Estado de Durango) and was part of the common vegetation associated with saline pools (Fig. 1b, c). The samples were collected from the rhizosphere of the halophyte saltgrass Distichlis spicata, grown from a natural saline soil with EC 10.12 mS cm−1 and 8.61 pH. Samples were collected aseptically using sterile spoons, transferred to sterile 15 ml conical tubes and transported to the laboratory at 4 °C into a cooler.
For isolation of bacteria, one gram of rhizospheric soil was taken and re-suspended in 9 ml of 0.5× PBS solution. The roots of Distichlis spicata (1 g fresh weight) were washed, surface sterilized with 1% sodium hypochlorite and rinsed five times with sterile 0.5× PBS, then the roots were macerated in a sterile mortar with 9 ml of PBS 0.5× solution for endophyte isolation. For rhizosphere and endophyte sampling, ten-fold serial dilutions were made and aliquots (100 μl) of serial dilutions were plated on different media: Free Nitrogen (NFb), King B (KB), Jensen, and Luria Bertani (LB) (Bertani 1951; Jensen 1987; King et al. 1954; Dobereiner and Day 1975; Vincent 1970). The plates were incubated at 30 °C for 1–3 days, and strains were selected based on colony morphology. Finally, the colonies were purified form their respective culture media and maintained in 30% glycerol solution at −80 °C.
2.2 Characterization of rhizobacterial effects in Arabidopsis thaliana
Arabidopsis thaliana (Col-0) seeds were disinfected with 20% sodium hypochlorite for 5 min and rinsed five times with sterile distilled water. The seeds were placed at 4 °C for 2 days for stratification. Then, 6 seeds were sown on Petri dishes containing 0.2× MS medium [1% (w/v) agar, 0.75% (w/v) sucrose, pH 7.0] and placed in a bioclimatic chamber at 25 ± 1 °C in a 16-h-light/8-h-dark cycle. After 4 days A. thaliana seedlings were inoculated with each rhizobacteria in a suspension of 2.5 × 108 CFU mL−1 by streaking on agar plates 5 cm below the plant roots tips. Plates were placed vertically at an angle of 70° to allow root growth along the agar surface. Experiments were performed in quadruplicate and after 12 days the evaluated parameters were: fresh weight, root length and lateral root number according to López-Bucio et al. (2007).
2.3 Plant growth-promoting traits in Cucumis sativus and Citrullus lanatus
Cucumber and watermelon seeds were surface-disinfected with 20% sodium hypochlorite for 5 min and rinsed five times with sterilized distilled water. Surface-disinfected seeds were germinated in a tray (200 inverted pyramid cells of 2.5 × 2.5 cm side length, 6 cm depth) filled with peat moss (Lambert peat moss, Inc. Quebec, Canada). Seven days after germination, the plantlets (five plantlets per treatment) were inoculated with each bacterial strain using 1 mL of 0.5× PBS suspension 1 × 108 CFU·mL−1 and grown twelve days at 25 °C under a 16-h-light/8-h-darkness cycle. The plantlets were irrigated with deionized water and maintained at field capacity and nutrients were supplied in a nutritive solution containing N 2311 (mg·L−1), Ca 626 (mg·L−1), Mg 1158 (mg·L−1), K 723 (mg·L−1), and micronutrients as traces. After 12 days, the cucumber and watermelon plantlets were harvested and root length, lateral roots numbers, and fresh weights of roots and shoots were measured.
2.4 Biochemical characterization of bacterial isolates
Phosphate solubilization was determined by Pikovskaya’s medium according to Goldstein (1986). Indole-3-acetic acid (IAA) analysis was done as reported by Bric et al. (1991). Siderophore production was determined by the Schwyn and Neilands (1987) method using CAS agar plates. ACC deaminase enzyme activity was carried out according to the method described by Penrose and Glick (2003).
Salinity resistance of the rhizobacteria was evaluated by observing the growth on LB medium supplemented with NaCl [5, 10, 15, and 20% (w/v)]. Control plates contained 1% NaCl (w/v). The plates were incubated for 24–48 h at 30 °C.
2.5 Salt tolerance experiments
A. thaliana (Col-0) seeds were disinfected into an Eppendorf tube with 20% sodium hypochlorite, shaking for 5 min and then rinsed with sterile distilled water four times. The seeds were placed at 4 °C for 2 days, then 5 seeds were transferred to the surface of Petri dishes supplemented with agar-solified 0.2× MS medium. The plates were incubated into a bioclimatic chamber with photoperiod of 16 h light/8 h darkness at 25 °C. 4 days after germination, five seedlings were transferred to another Petri plate containing fresh medium supplemented with 100 or 200 mM NaCl, and a 2.5 × 108 CFU mL−1 suspension was inoculated 5 cm below the root tips. The plates were placed again in the bioclimatic chamber and after 5 days, the length of the primary root and total weight of the seedlings were measured (Salas-Muñoz et al. 2012; Contreras-Cornejo et al. 2014).
2.6 16S rRNA analysis
Rhizobacteria were subjected to 16S rRNA gene sequence analysis. The DNA was extracted by CTAB technique following the method from Doyle and Doyle (1990). Amplification of 16S rRNA gene was made by PCR using universal bacterial primers 27F 5’AGAGTTTGATCMTGGCTCAG3’ and 1492R 5’GGTTACCTTGTTACGACTT3`, the PCR product was purified using the AxyPrep DNA gel Extraction kit (Axygen) and then sequenced by McLAB, San Francisco, CA. The sequences obtained were compared using the BLAST (NCBI) (http://blast.ncbi.nlm.nih.gov/Blast.cgi) algorithm to determine the taxonomy of the bacterial strains (Weisburg et al. 1991; Altschul et al. 1997). Neighbour-joining analysis was performed using the MEGA software packages (Version 6.06) after alignments of data by CLUSTAL W. The relationships among sequences were analyzed by neighbor-joining method and bootstrap analysis with 1000 randomized data set (Felsenstein 1985; Saitou and Nei 1987; Kumar et al. 2008; Hall 2013).
2.7 PCR amplification of the nifH and acdS genes
The nifH genes were amplified from DNA extracted from rhizobacteria (LBEndo1 and KBEcto4). The primers PolF (5’TGCGAYCCSAARGCBGACTC3´) and PolR (5’ATSGCCATCATYTCRCCGGA3´) amplify a 360 bp fragment of the nifH gene (Poly et al. 2001). For PCR amplification of acdS genes, the primers used were F1937F (5’MGVAAGCTCGAATAYMTBRT3’) and F1939R (5’GARGCRTCGAYVCCRATCAC3’) with an 800 bp amplification PCR product (Blaha et al. 2006).
2.8 Histochemical analysis of DR5::GUS activity
The DR5::GUS Arabidopsis thaliana seedlings were germinated and grown four days on 0.2× MS medium and then transferred to fresh 0.2× MS agar plates, directly placed over the bacterial streak. After six days in co-cultivation, the seedlings were collected and incubated in 12 well, cell culture plates with an X-Gluc 0.1% (5-bromo-4-chloro-3-indolyl-β-D-glucoronide) dissolution in a phosphate buffer (NaH2PO4 Na2HPO4 to 0.1 M and pH 7) with K4Fe(CN)6 and K3Fe(CN)6 at 2 mM for 12 h at 37 °C (Jefferson et al. 1987). After this time, the tissue was cleared as reported by Malamy and Benfey (1997). The stained seedlings were individually placed on glass slides and observed with Normaski optics on a Leica DMR5000 microscope.
2.9 Statistical analysis
The different plant developmental parameters (root length, lateral root number, root and shoot weight) were analyzed in a random experimental design, and a statistical analysis of ANOVA followed by a T test Tukey (HSD) with P = 0.05 was applied. Analyses were made using statistical add-in for Microsoft Excel (XLSTAT).
3 Results
3.1 Isolation of rhizobacteria from Distichlis spicata
A total of 75 bacterial strains were isolated and typified based on colonial morphology and recovered via successive subculturing. The cultivable population consisted of 44 isolates from the rhizosphere, from which 12, 16, 11, and 5 strains were isolated using Luria Bertani, King’s B, Jensen’s N-Free, and Nitrogen Fixing bacteria medium, respectively. 31 strains were isolated as endophytes, and 9 strains were propagated using Luria Bertani, 9 on King’s B, 5 on Jensen’s N-Free, and 8 on Nitrogen Fixing bacteria media. The isolated strains were named based on the medium used for isolation and the rhizosphere zone of origin and serial arbitrary number of the strain (i.e. LBEndo1).
3.2 Effects of inoculation with selected D. spicata rhizobacteria on growth of Arabidopsis thaliana, Cucumis sativus, and Citrullus lanatus
To determine their possible PGPR properties, 38 rhizobacterial strains were co-cultivated with Arabidopsis seedlings in vitro. Their effects on plant growth were quite diverse, ranging from positive (biostimulant) to negative (deleterious) or neutral (Supplemental Table 1). The two most promising rhizobacterial strains, namely LBEndo1 and KBEcto4, were selected following their strong shoot and root biostimulation (Fig. 2a–c). Twelve days after inoculation, the growth of primary roots of seedlings co-cultivated with LBEndo1 and KBEcto4 was reduced (Fig. 2d), whereas the number of lateral roots increased (Fig. 2e). These root architectural changes correlated with a two-to-three-fold increase in fresh weight of seedlings (Fig. 2f). Additionally, Arabidopsis seedlings inoculated with LBEndo1 and KBEcto4 increased the development of root hairs, a trait very important for water and nutrient acquisition (Supplemental Fig. 1b, c). Proliferation of bacteria over the primary root was observed without causing apparent damage to the root (Supplemental Fig. 1c).
Effect of inoculation of LBEndo1 and KBEcto4 rhizobacteria on growth of Arabidopsis thaliana (Col-0) seedlings. a Photographs of 12 d old Arabidopsis seedlings grown on 0.2× MS medium agar plates without bacteria (Control). b Arabidopsis plants co-cultivated with LBEndo1 or c KBEcto4 rhizobacteria strains, respectively. d Primary root length. e Lateral root number. f Total fresh weight. Values represent the mean ± standard deviation of 24 seedlings grown in four independent plates. Different letters indicate statistically significant difference (P < 0.05)
Inoculation of cucumber (Cucumis sativus) seedlings with LBEndo1 and KBEcto4 strains and cultivation in a soil substrate composed with peat moss significantly improved the root length, the number of lateral roots and the root and shoot weights compared to seedlings without bacteria (Fig. 3). Twelve days after inoculation LBEndo1 and KBEcto4 isolates increased root length by 49 and 44% (Fig. 3b), the number of lateral roots increased 132 and 108% (Fig. 3c), root fresh weight increased by 202 and 174% (Fig. 3e), and shoot fresh weight by 52 and 43%, respectively (Fig. 3d). Inoculation of watermelon (Citrullus lanatus) seedlings with LBEndo1 and KBEcto4 in pots with peat moss as substrate improved root length by 32 and 46% (Fig. 3b ), while increasing the number of lateral roots by 76 and 93% (Fig. 3c), shoot fresh weights by 35 and 22% (Fig. 3d), and root fresh weights 90 and 63% (Fig. 3e) respectively, compared to seedlings without bacteria (Fig. 3a–e). These data show that the PGPR properties of LBEndo1 and KBEcto4 isolates also occur in horticultural crops.
Effect of inoculation of LBEndo1 and KBEcto4 PGPR on growth of Cucumis sativus cv. Mondan and Citrullus lanatus cv. Peacock seedlings. a Photographs of cucumber (left) and watermelon (right) seedlings twelve days after LBEndo1 and KBEcto4 inoculation. b Primary root length. c Lateral root number. d Shoot fresh weight, e Root fresh weight. Values represent the mean ± standard deviation of 5 seedlings grown in three independent experiments. Different letters indicate significant difference (P < 0.05)
3.3 Effect of inoculation of rhizobacteria on Arabidopsis thaliana growth under saline conditions
To determine if LBEndo1 and KBEcto4 could confer salt tolerance and explore possible mechanisms of biostimulation, the Arabidopsis response to salt was tested in vitro, under axenic conditions or co-cultivated with these bacteria. After seven days in MS 0.2× medium with 100 mM NaCl the Arabidopsis seedlings with bacterial co-cultivation show enhanced root growth (Fig. 4a, d), as well as increased biomass production (Fig. 4b) and foliar area than axenically grown seedlings (Fig. 4c, d). Arabidopsis seedlings treated with 200 mM NaCl were severely affected in growth and development by the stress imposed, however, inoculation with LBEndo1 and KBEcto4 still conferred protection from salinity since the primary root was able to grow and the fresh weigh was 78 and 111% greater than in non-inoculated seedlings (Fig. 4a, b). These data indicate that the bacteria improve growth of Arabidopsis seedlings under salt stress.
Effect of inoculation of LBEndo1 and KBEcto4 rhizobacteria on growth of Arabidopsis thaliana (Col-0) seedlings under saline conditions. a Primary root length, and b Total fresh weight. Dark bars are parameters representing 100 mM NaCl and light grey bars represent 200 mM NaCl treatments, respectively. c Representative photograph of Arabidopsis seedlings exposed to 100 mM NaCl without bacteria (Control), or d inoculated with KBEcto4. Values represent the mean of four plates per treatments of 5 seedlings ± standard deviation. Different letters indicate significant difference (P < 0.05)
3.4 Biochemical and plant beneficial traits of rhizobacteria
The LBEndo1 and KBEcto4 strains showed IAA production when cultivated in L-tryptophan (Trp)-supplemented media in amounts from 23.4 and 36.7 μg/ml, respectively (Table 1). The siderophore production was evaluated by CAS medium, in which LBEndo1 and KBEcto4 developed orange halos surrounding the colonies, thus confirming the siderophore production (Table 1). The rhizobacteria solubilized phosphate as revealed by the production of clear halos surrounding colonies grown in Pikovskaya medium by LBEndo1 and KBEcto4, respectively (Table 1). The activity of ACC deaminase was colorimetrically assessed, as a result, only the KBEcto4 rhizobacteria strain was able to grow in medium containing ACC, implying ACC deaminase production. Based on the enzymatic ACC deaminase activity, the KBEcto4 was able to produce around 91 nmole α-ketobutyrate/h/mg protein of cell pellet in medium with ACC as sole nitrogen source. Importantly, the LBEndo1 and KBEcto4 strains were able to grow in the medium supplemented with 15% NaCl (Table 1). These biochemical properties likely account for their PGPR properties either under standard growth conditions or when exposed to salinity.
3.4.1 nifH and acdS gene analysis
The LBEndo1 and KBEcto4 strains were PCR assessed for nifH and acdS gene presence. No amplification product was observed for nifH gene in any of the bacterial strains (Table 1). To determine the presence of the ACC deaminase gene and the possible ability to reduce the amount of ethylene inside plant tissues, amplification by PCR of the acdS gene was evaluated. Consistently, only the KBEcto4 produced the 800-pb PCR amplification product (Table 1). This result supports the ACC deaminase activity assay for KBEcto4 strain.
3.5 Identification of LBEndo1 and KBEcto4 strains by 16S rRNA sequencing
The 16S rRNA sequence obtained were subjected to homology analysis via BLAST (NCBI Database), which retrieves taxonomic positions of rhizobacteria strains, LBEndo1 amplification sequence is similar to that of Bacillus paralicheniformis with an homology of 96% and KBEcto4 exhibited 99% homology with Pseudomonas lini (Table 2). According to 16S rRNA gene sequence-based Neighbor-joining tree (Fig. 5a–b), the LBEndo1 PGPR strains were separated into two groups corresponding to B. amyloliquefaciens group and B. licheniformis group, the above group was close to LBEndo1 and species belonging to this group were B. licheniformis, B. sonorensis, B. paralicheniformis, and B. aerius (Fig. 5a). 16S rRNA gene sequence-based Neighbor-joining tree of KBEcto4 PGPR strain was closely related to Pseudomonas mediterranea and was located in P. lini, P. veronii, P. prosekii, and P. arsenicoxydans species group (Fig. 5b).
Neighbour-joining trees based on partial 16S rRNA gene sequence. a Tree shown the relationship of LBEndo1 PGPR strain to closely related bacteria recovered from GenBank. b Tree shown the relationship of KBEcto4 PGPR strain to closely related bacteria recovered from GenBank. Black triangles indicate the PGPR strains isolated from Distichlis spicata rhizosphere. Values above each node are bootstrap percentages obtained from 1000 replicates
3.6 Differential effects of LBEndo1 and KBEcto4 rhizobacteria on auxin signaling in Arabidopsis
Auxins are the canonical signals for regulation of root architecture. Since LBEndo1 and KBEcto4 have the common characteristics of promoting lateral root and root-hair development, we next investigated if these effects could be due to a possible auxin changes, via monitoring the expression of the auxin inducible DR5::GUS synthetic reporter. Unexpectedly, the inoculation with LBEndo1 drastically reduced the expression of this reporter in the shoot meristem, root meristem, and lateral roots (Fig. 6d–f) compared to axenic controls (Fig. 6a–c). The inoculation of the KBEcto4 strain reduced the DR5::GUS expression in the shoot system, but slightly increased the auxin-inducible expression in the root meristem (Fig. 6g–i). These data indicate that the rhizobacteria influence auxin signaling in Arabidopsis in different ways.
Effect of LBEndo1 and KBEcto4 PGPR strains on DR5::GUS expression. Seedlings were grown on 0.2× MS medium plates and after six days of Arabidopsis-PGPR interaction transgenic seedlings expressing DR5::GUS were assayed for histochemical GUS activity. a–c, control non-inoculated DR5::GUS seedlings. a shoot, b lateral roots, and c primary roots. d–f LBEndo1-inoculated DR5::GUS seedlings, d shoot, e lateral roots, and f primary roots. g–i, KBEcto4-inoculated DR5::GUS seedlings, g shoot, h lateral roots, and i primary roots
4 Discussion
The rhizosphere contains microorganisms that can strongly influence plant growth and development (Glick 1995; Glick et al. 1998). In the present study, we characterized two bacterial species isolated from Distichlis spicata rhizosphere, with the ability to stimulate growth in Arabidopsis thaliana, Cucumis sativus, and Citrullus lanatus seedlings.
A clear phytostimulation for Arabidopsis thaliana seedlings in vitro was observed after twelve days of inoculation with LBEndo1 and KBEcto4 rhizobacteria, which coincided with root architecture remodeling via changes in main root growth, as well as lateral root and root-hair formation. The primary root growth inhibition was first reported among the root architectural traits influenced by PGPR Bacillus megaterium (López-Bucio et al. 2007) and later by Phyllobacterium brassicacearum (Contesto et al. 2010). Shi et al. (2010) studied the interaction Arabidopsis-Serratia marcescens strain 90–166 and observed inhibition of primary root elongation, increased lateral root emergence, and early emergence of second order lateral roots. The PGPR Pseudomonas fluorescens WCS417 also had inhibitory effects over primary root growth followed by the prominent stimulation of lateral root formation (Zamioudis et al. 2013), a property ubiquitously maintained during the interaction of Arabidopsis with Bacillus amyloliquefaciens subsp. plantarum UCMB5113 (Asari et al. 2016). It is possible that the inhibition of root growth is the initial developmental trait influenced by diffusible or volatile bacterial metabolites and that enhanced lateral root formation may occur as a consequence of main root growth stoppage or in a process regulated independently.
The Arabidopsis inoculation with LBEndo1 and KBEcto4 strains increased the number and length of root hairs, an agricultural trait with tremendous importance for acquisition of water and nutrient resources. The inoculation with diverse PGPR causes overproduction of root hairs via release of phytohormones, mainly auxin, ethylene and/or cytokinin (López-Bucio et al. 2007; Contesto et al. 2010; Shi et al. 2010; Zamioudis et al. 2013; Asari et al. 2016). Indeed, we demonstrate that the beneficial effects of salt tolerant rhizobacteria extend beyond the Arabidopsis model since LBEndo1 and KBEcto4 promote growth and improve root development of Cucumis sativus and Citrullus lanatus in a soil substrate.
In vitro studies using Arabidopsis seedlings are very basic for genetic research and have been instrumental to identify the molecular mechanisms of bacteria-plant recognition. Since PGPR also interact with crop plants in agricultural systems and translational biology of plant-microbe interactions is an urgent necessity to incorporate living bioinoculants to improve crop performance in different environments, it is important to validate that the biostimulating effects of bacterial isolates also occur in economically important plant species. In this regard, our data and those of Gül et al. (2013), which demonstrated the value of Pseudomonas putida strain 18/1 K and Serratia marcescens strain 62 inoculation on cucumber productivity, highlight the potential of use PGPR in horticulture.
Our analysis of the expression of the auxin-inducible DR5::GUS gene marker in transgenic A. thaliana seedlings, show the highly contrasting influences of PGPR on the plant auxin signaling pathway. Neither LBEndo1 nor KBEcto4 strain could increase an auxin response in the shoot system and only KBEcto4 slightly increases DR5::GUS in primary root tips. Similarly, Arabidopsis seedlings inoculated with Bacillus megaterium increased the growth of lateral roots mediated by auxin redistribution more than the possible auxin overaccumulation (López-Bucio et al. 2007). In contrast, Bacillus spp. LZR216 enhanced DR5::GUS signaling in primary root tips linked to increased auxin levels (Wang et al. 2016). These results indicate that diverse PGPR may similarly affect root architecture, but via different mechanisms, or through the combination of mechanisms rather than a single mechanism explain their phytostimulation properties. Small cyanide concentrations produced by pseudomonads strains may explain the inhibition of DR5::GUS expression and the reduced growth of the primary root (Rudrappa et al. 2008). Therefore, PGPR do not need to produce high amounts of auxins to increase the growth and development of lateral roots and root hairs, root morphogenesis is certainly a complex trait that involves integration of diverse components and signs.
Soil salinization is one of the major agricultural problems affecting approximately 400 million hectares of cropland. Salinity has a strong growth suppressing effect on plants (Bot et al. 2000; FAO 2002; Khan and Panda 2008). Some reports have shown the protective effects of fungal symbionts to salinity on crops such as maize (Hamdia et al. 2004; Nadeem et al. 2007), lettuce (Barassi et al. 2006), mung bean (Ahmad et al. 2013), and potato (Gururani et al. 2013). InIndeed bacteria can protect plants from the effects of salt and drought stresses via production of IAA, ACC deaminase, abscisic acid, cytokinin, volatile organic compounds and exopolysaccharides (Kim et al. 2014; Forni et al. 2017). Our demonstration that two rhizobacterial strains improve plant growth under salinity conditions (NaCl 100 and 200 mM) highlights the potential of halophytic plant rhizospheres as a resource of salt adapted PGPR.
The fact that the KBEcto4 rhizobacteria strain grows on DF medium with ACC, indicates its ability to cleave the ethylene precursor ACC and thereby to reduce the endogenous ethylene level of plants. Bacteria with ACC deaminase are recognized as important for plants to adapt to abiotic and biotic stresses (Saravanakumar and Samiyappan 2007). Ali et al. (2014) evidenced the importance of bacteria with ACC deaminase to salt stress protection in plants, the authors studied the endophytes Pseudomonas fluorescens YsS6, Pseudomonas migulae 8R6 and their corresponding ACC deaminase deficient mutants to promote tomato plant growth under salt stress, and found that wild-type endophytes protected plants from salt stress, but not the ACC deaminase deficient mutants. In this study, we show that the KBEcto4 strain harbors the ACC deaminase gene (acdS) and possess activity of ACC deaminase, which may account for its PGPR properties potentially useful when co-cultivated with plants under salt stress. Penrose and Glick (2003) proposed that a low level of ACC deaminase activity is promising to promote plant growth and typify a bacterial isolate as PGPR. Qin et al. (2014) isolated four rhizobacteria (KLBMP 4941, KLBMP 4942, KLBMP 5180, and KLBMP 5084) from the halophyte Limonium sinense, which presented high ACC deaminase activity, a trait that correlate with an improved seed germination and performance under salt stress. Similar levels of ACC deaminase activity to our study were observed in Methylobacterium fujisawaense strains CBMB20 and CBMB110 with 94.48 and 24.74 μmol α-KB/h/mg Pr, respectively, these strains could promote root elongation in canola seedling under gnotobiotic conditions (Madhaiyan et al. 2006). It is possible however, that increased growth of plants treated with PGPR inoculants is more likely due to a combination of mechanisms more than being the result of a single mechanism, since many desirable traits are ubiquitously present in LBEndo1 and KBEcto4. Consistently, LBEndo1 and KBEcto4 strains, which belong into Bacillus sp. and Pseudomonas lini taxa, respectively can grow in culture media with a high salt concentration (NaCl 15%) and also presents siderophore production and phosphate solubilization properties. Although more studies are needed to continue the prospection of the bacterial collection isolated from D. spicata, characterization of the phytostimulant ability of these two halophilic PGPR strains reveals the promising potential of halophilic rhizobacteria as plant growth promoters under standard and saline conditions.
References
Ahmad M, Zahir A, Khalid M, Nazli F, Arshad M (2013) Efficacy of Rhizobium and Pseudomonas strains to improve physiology, ionic balance and quality of mung bean under salt-affected conditions on farmer’s fields. Plant Physiol Biochem 63:170–176
Ali S, Charles TC, Glick BR (2014) Amelioration of high salinity stress damage by plant growth promoting bacterial endophytes that contain ACC deaminase. Plant Physiol Biochem 80:160–167
Allen EB, Cunningham GL (1983) Effects of vesicular-arbuscular mycorrhizae on Distichlis spicata under three salinity levels. New Phytol 93:227–236
Altschul SF, Madden TL, Schaffer AA, Zhang J, Zhang Z, Miller W, Lipman DJ (1997) Gapped BLAST and PSI-BLAST: a new generation of protein database search programs. Nucleic Acids Res 25:3389–3402
Asari S, Tarkowská D, Rolcık J, Novak O, Velázquez-Palmero D, Bejai S, Meijer J (2016) Analysis of plant growth-promoting properties of Bacillus amyloliquefaciens UCMB5113 using Arabidopsis thaliana as host plant. Planta. doi:10.1007/s00425-016-2580-9
Barassi CA, Ayrault G, Creus CM, Sueldo RJ, Sobero MT (2006) Seed inoculation with Azospirillum mitigates NaCl effects on lettuce. Sci Hortic 109:8–14
Bashan Y, de-Bashan LE (2010) How the plant growth-promoting bacterium Azospirillum promotes plant growth a critical assessment. Adv Agron 108:77–136
Berendsen RL, Pieterse CM, Bakker PA (2012) The rhizosphere microbiome and plant health. Trends Plant Sci 17:478–486
Bertani G (1951) STUDIES ON LYSOGENESIS I. : the mode of phage liberation by lysogenic Escherichia coli. J Bacteriol 62:293–300
Bhattacharyya PN, Jha DK (2012) Plant growth-promoting rhizobacteria (PGPR): emergence in agriculture. World J Microbiol Biotechnol 28:1327–1350
Blaha D, Prigent-Combaret C, Mirza MS, Moënne-Loccoz Y (2006) Phylogeny of the 1-aminocyclopropane-1-carboxylic acid deaminase-encoding gene acd S in phytobeneficial and pathogenic Proteobacteria and relation with strain biogeography. FEMS Microbiol Ecol 56:455–470
Bot AJ, Nachtergaele FO, Young A (2000) Land resource potential and constrains at regional and country levels. World Soil Resources Reports. 90, Land and Water Development Division, Food and Agriculture Organization of the United Nations, Rome, Italy
Bric JM, Bostock RM, Silverstone SE (1991) Rapid In Situ assay for indoleacetic acid production by bacteria immobilized on a nitrocellulose membrane. Appl Environ Microbiol 57:535–538
Contesto C, Milesi S, Mantelin S, Zancarini A, Desbrosses G, Varoquaux F, Bellini C, Kowalczyk M, Touraine B (2010) The auxin-signaling pathway is required for the lateral root response of Arabidopsis to the rhizobacterium Phyllobacterium brassicacearum. Planta 232:1455–1470
Contreras-Cornejo HA, Macias-Rodriguez L, Alfaro-Cuevas R, López-Bucio J (2014) Trichoderma spp. improve growth of Arabidopsis seedlings under salt stress through enhanced root development, osmolite production, and Na(+) elimination through root exudates. Mol. Plant Microbe Interact 27:503–514
Czaja A, Estrada-Rodríguez JL, Flores-Olvera H (2014) The gypsum dunes of Cuatrociénegas valley, Mexico, a secondary ecosystem with Gypsophytes. In: Ajmal Khan M, Böer B, Öztürk M, Al Abdessalaam TZ, Clüsener-Godt M, Gul B (eds) Cash crop halophyte and biodiversity conservation, vol 4. Springer, Dordrecht, Heidelberg, New York, London, pp 81–92
Dimkpa C, Weinand T, Asch F (2009) Plant rhizobacteria interactions alleviate abiotic stress conditions. Plant Cell Environ 32:1682–1694
Dobereiner J, Day J (1975) Associative symbiosis in tropical grasses: characterization of microorganisms and dinitrogen fixing sites. Proceedings of the 1st International Symposium on Nitrogen Fixation, (SNF’ 75). Washington State University Press, Pullman, pp 518–538
Doyle JJ, Doyle JL (1990) Isolation of plant DNA from fresh tissue. Focus 12:13–15
Eppley SM, Mercer CA, Haaning C, Graves CB (2009) Sex-specific variation in the interaction between Distichlis spicata (Poaceae) and mycorrhizal fungi. Am J Bot 96:1967–1973
Felsenstein J (1985) Confidence limits on phylogenies: an approach using the bootstrap. Evolution 39:783–791
Figueiredo VB, Burity HA, Martinez CR, Chanway CP (2008) Alleviation of water stress effects in common bean (Phaseolus vulgaris L.) by co-inoculation Paenibacillus x Rhizobium tropici. Appl Soil Ecol 40:182–188
Forni C, Duca D, Glick BR (2017) Mechanisms of plant response to salt and drought stress and their alteration by rhizobacteria. Plant Soil 410:335–356
Glick BR (1995) The enhancement of plant growth by free-living bacteria. Can J Microbiol 41:109–117
Glick BR, Penrose DM, Jiping L (1998) A model for the lowering of plant ethylene concentrations by plant growth-promoting bacteria. J Theor Biol 190:63–68
Goldstein AH (1986) Bacterial solubilization of mineral phosphates: historical perspectives and future prospects. Am J Altern Agric 1:51–57
Gül A, Özaktan H, Kıdoğlu F, Tüzel Y (2013) Rhizobacteria promoted yield of cucumber plants grown in perlite under Fusarium wilt stress. Sci Hortic 153:22–25
Gururani MA, Upadhyaya CP, Baskar V, Venkatesh J, Nookaraju A, Park SW (2013) Plant growth-promoting rhizobacteria enhance abiotic stress tolerance in Solanum tuberosum through inducing changes in the expression of ROS-scavenging enzymes and improved photosynthetic performance. J Plant Growth Regul 32:245–258
Hall BG (2013) Building phylogenetic trees from molecular data with MEGA. Mol Biol Evol 30:1229–1235
Hamdia ES, Shaddad AK, Doaa MM (2004) Mechanisms of salt tolerance and interactive effects of Azospirillum brasilense inoculation on maize cultivars grown under salt stress conditions. Plant Growth Regul 44:165–174
Hansen DJ, Dayanadan P, Kaufman PB, Brotherson JD (1976) Ecological adaptation of salt marsh grass, Distichlis spicata (Gramineae) and environmental factors affecting its growth and distribution. Am J Bot 63:635–650
Hayat R, Ali S, Amara U, Khalid R, Ahmed I (2010) Soil beneficial bacteria and their role in plant growth promotion: a review. Ann Microbiol 60:579–598
Hitchcock AS (1971) Manual of the grasses of the United States. Dover, New York
Jamil A, Riaz S, Ashraf M, Foolad MR (2011) Gene expression profiling of plants under salt stress. Crit Rev Plant Sci 30:435–458
Jefferson RA, Kavanagh TA, Bevan MW (1987) GUS fusion: β-glucoronidase as a sensitive and versatile fusion marker in higher plants. EMBO J 6:3901–3907
Jensen ES (1987) Inoculation of pea by application of Rhizobium in planting furrow. Plant Soil 97:63–70
Jha B, Gontia I, Hartmann A (2012) The roots of the halophyte Salicornia brachiata are a source of new halotolerant diazotrophic bacteria with plant growth-promoting potential. Plant Soil 356:265–277
Khan MH, Panda SK (2008) Alterations in root lipid peroxidation and antioxidative responses in two rice cultivars under NaCl salinity stress. Acta Physiol Plant 30:89–91
Kim K, Jang YJ, Lee SM, Oh BT, Chae JC, Lee KJ (2014) Alleviation of salt stress by Enterobacter sp. EJ01 in tomato and Arabidopsis is accompanied by up-regulation of conserved salinity responsive factors in plants. Mol Cell 37:109–117
King E, Ward W, Ramy D (1954) Two simple media for the demonstration of pyocyanin and fluorescence. J Lab Clin Med 44:301–307
Kloepper JW, Schroth MN (1978) Plant growth promoting rhizobacteria on radishes. In: Proceedings of IVth International Conference on Plant Pathogenic Bacteria. p 879–882
Kumar S, Nei M, Dudley J, Tamura K (2008) MEGA: a biologist-centric software for evolutionary analysis of DNA and protein sequences. Brief Bioinform 9:299–306
López-Bucio J, Campos-Cuevas JC, Hernández-Calderón E, Velásquez-Becerra C, Farías-Rodríguez R, Macías-Rodríguez LI, Valencia-Cantero E (2007) Bacillus megaterium Rhizobacteria promote growth and alter root-system architecture through an auxin- and ethylene-independent signaling mechanism in Arabidopsis thaliana. Mol Plant-Microbe Interact 20:207–217
Madhaiyan M, Poonguzhali S, Ryu J, Sa T (2006) Regulation of ethylene levels in canola (Brassica campestris) by 1-aminocyclopropane-1-carboxylate deaminase-containing Methylobacterium fujisawaense. Planta 224:268–278
Malamy J, Benfey P (1997) Down and out in Arabidopsis: the formation of lateral roots. Trends Plant Sci 2:390–401
Mapelli F, Marasco R, Rolli E, Barbato M, Cherif H, Guesmi A, Ouzari I, Daffonchio D, Borin S (2013) Potential for plant growth promotion of rhizobacteria associated with Salicornia growing in Tunisian hypersaline soil. Biomed Res Int 2013:248078
Mayak S, Tirosh T, Glick BR (2004) Plant growth-promoting bacteria confer resistance in tomato plants to salt stress. Plant Physiol Biochem 42:565–572
Munns R (2005) Genes and salt tolerance: bringing them together. New Phytol 167:645–663
Nadeem SM, Zahir ZA, Naveed M, Arshad M (2007) Preliminary investigations on inducing salt tolerance in maize through inoculation with rhizobacteria containing ACC deaminase activity. Can J Microbiol 53:1141–1149
Newton AC, Fitt BD, Atkins SD, Walters DR, Daniell TJ (2010) Pathogenesis, parasitism and mutualism in the trophic space of microbe–plant interactions. Trends Microbiol 18:365–373
Penrose DM, Glick BR (2003) Methods for isolating and characterizing ACC deaminase-containing plant growth-promoting rhizobacteria. Physiol Plant 118:10–15
Poly F, Monrozier LJ, Bally R (2001) Improvement in the RFLP procedure for studying the diversity of nif H genes in communities of nitrogen fixers in soil. Res Microbiol 152:95–103
Qin S, Zhang YJ, Yuan B, Xu PY, Xing K, Wang J, Jiang JH (2014) Isolation of ACC deaminase-producing habitat-adapted symbiotic bacteria associated with halophyte Limonium sinense (Girard) Kuntze and evaluating their plant growth-promoting activity under salt stress. Plant Soil 374:753–766
Ram A, Zaccai M, Pasternak D, Bustan A (2004) Analysis of phenotypic and genetic polymorphism among accessions of saltgrass (Distichlis spicata). Genet Resour Crop Evol 51:687–699
Rudrappa T, Czymmek KJ, Paré PW, Bais HP (2008) Root-secreted malic acid recruits beneficial soil bacteria. Plant Physiol 148:1547–1556
Saitou N, Nei M (1987) The neighbor-joining method: a new method for reconstructing phylogenetic trees. Mol Biol Evol 4:406–425
Salas-Muñoz S, Gómez-Anduro G, Delgado-Sánchez P, Rodríguez-Kessler M, Jiménez-Bremont JF (2012) The Opuntia streptacantha OpsHSP18 gene confers salt and osmotic stress tolerance in Arabidopsis thaliana. Int J Mol Sci 13:10154–10175
Saravanakumar D, Samiyappan R (2007) ACC deaminase from Pseudomonas fluorescens mediated saline resistance in groundnut (Arachis hypogea) plants. J Appl Microbiol 102:1283–1292
Schwyn B, Neilands JB (1987) Universal chemical assay for the detection and determination of siderophores. Anal Biochem 160:47–56
Shi CL, Park HB, Lee JS, Ryu S, Ryu CM (2010) Inhibition of primary roots and stimulation of lateral root development in Arabidopsis thaliana by the rhizobacterium Serratia marcescens 90-166 is through both auxin-dependent and -independent signaling pathways. Mol Cell 29:251–258
Siddikee MA, Chauhan PS, Anandham R, Gwang-Hyun H, Sa T (2010) Isolation, characterization, and use for plant growth promotion under salt stress, of ACC deaminase-producing halotolerant bacteria derived from coastal soil. J Microbiol Biotechnol 20:1577–1584
Swain MR, Ray RC, Nautiyal CS (2008) Biocontrol efficacy of Bacillus subtilis strains isolated from cow dung against postharvest yam (Dioscorea rotundata L.) pathogens. Curr Microbiol 57:407–411
The Food and Agriculture Organization of the United Nations (FAO) (2002) Crops and drops: making the best use of water for agriculture. FAO, Rome http://fao.org/docrep/w5146e/w5146e0a.htm
The Food and Agriculture Organization of the United Nations (FAO) (2008) FAO Land and Plant Nutrition Management Service http://www.fao.org/ag/agl/agll/spush/
Tian Y, Gao L (2014) Bacterial diversity in the rhizosphere of cucumbers grown in soils covering a wide range of cucumber cropping histories and environmental conditions. Microb Ecol 68:794–806
Ungar IA (1974) Inland halophytes of the United States. In: Queen WH, Reinold RJ (eds) Ecology of halophytes. Academic Press Inc, NY & London, pp 235–305
Vincent J (1970) A Manual for the practical study of Root-Nodule Bacteria, Blackwell 422 Scientific, Oxford. I.B.P Handbook, 15
Wang J, Zhang Y, Li Y, Wang X, Liu Z, Nan W, Zhao C, Wang F, Ma J, Bi Y (2016) Involvement of polar auxin transport in the inhibition of Arabidopsis seedling growth induced by Stenotrophomonas maltophilia. Biol Plant 60:299–310
Weisburg W, Barns S, Pelletier D, David P, Gene L (1991) 16s ribosomal DNA amplification for phylogenetic study. J Bacteriol 173:697–703
Zamioudis C, Mastranesti P, Dhonukshe P, Blilou I, Pieterse CMJ (2013) Unraveling root developmental programs initiated by beneficial Pseudomonas spp. bacteria. Plant Physiol 162:304–318
Acknowledgements
We thank Alexander Czaja and Jose Luis Estrada Rodríguez for his kind invitation to sample the “Poza Salada” pool in the Valley of Sobaco. This research was supported by PRODEP-SEP project (DSA/103.5/15/3004).
Author contributions
P.R.R.; J.S.M.; J.L.B. Designed the concept, discussed results and wrote the manuscript. P.R.R., C.A.J.L., S.S.J., M.P.G., C.G.G.; J.S.M. performed experiments, and analyzed data.
Author information
Authors and Affiliations
Corresponding author
Electronic supplementary material
ESM 1
(DOCX 151 kb)
Supplemental Fig. 1
Effect of LBEndo1 and KBEcto4 PGPR strains on root hair growth. Primary root tips of control non-inoculated, bacterized Arabidopsis seedlings germinated and grown 6 days on 0.2× MS medium plates. a, non-inoculated root tip, b and c, Primary root tips of PGPR inoculated Arabidopsis seedlings inoculated with LBEndo1, or KBEcto4, respectively. Note the increased growth of root hairs following bacterial root proliferation. (TIFF 118 kb)
Rights and permissions
About this article
Cite this article
Palacio-Rodríguez, R., Coria-Arellano, J.L., López-Bucio, J. et al. Halophilic rhizobacteria from Distichlis spicata promote growth and improve salt tolerance in heterologous plant hosts. Symbiosis 73, 179–189 (2017). https://doi.org/10.1007/s13199-017-0481-8
Received:
Accepted:
Published:
Issue Date:
DOI: https://doi.org/10.1007/s13199-017-0481-8